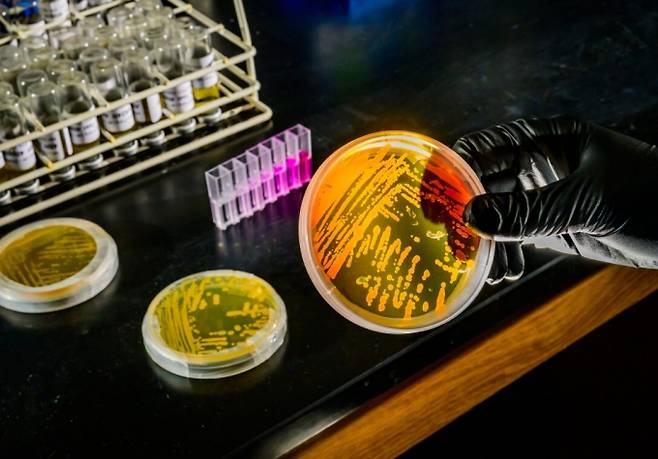
(사진=일리노이대학 어바나-샴페인 홈페이지)

온난화로 심해까지 '뜨끈'...미생물은 오히려 활발해진다?
전체 맥락을 이해하기 위해서는 본문 보기를 권장합니다.
온난화가 심해까지 수온이 올라가면서 해양생태계 변화에 대한 우려가 커지고 있는 가운데, 해양 미생물 일부가 이러한 환경변화에 적응하고 있을 가능성이 제기됐다.
11일(현지시간) 미국 일리노이대학 어바나-샴페인 캠퍼스와 남가주대학(USC) 연구팀은 해양 미생물 '니트로소푸밀루스 마리티무스(Nitrosopumilus maritimus)'가 높은 수온과 낮은 영양 조건에서도 생존할 수 있도록 대사 방식을 조절하는 능력을 보이고 있다는 연구결과를 발표했다.
이 글자크기로 변경됩니다.
(예시) 가장 빠른 뉴스가 있고 다양한 정보, 쌍방향 소통이 숨쉬는 다음뉴스를 만나보세요. 다음뉴스는 국내외 주요이슈와 실시간 속보, 문화생활 및 다양한 분야의 뉴스를 입체적으로 전달하고 있습니다.
온난화가 심해까지 수온이 올라가면서 해양생태계 변화에 대한 우려가 커지고 있는 가운데, 해양 미생물 일부가 이러한 환경변화에 적응하고 있을 가능성이 제기됐다.
11일(현지시간) 미국 일리노이대학 어바나-샴페인 캠퍼스와 남가주대학(USC) 연구팀은 해양 미생물 '니트로소푸밀루스 마리티무스(Nitrosopumilus maritimus)'가 높은 수온과 낮은 영양 조건에서도 생존할 수 있도록 대사 방식을 조절하는 능력을 보이고 있다는 연구결과를 발표했다.
이 미생물은 해양 플랑크톤의 약 30%를 차지하는 고세균(archaea)으로, 바다의 질소 순환을 담당하는 핵심으로 알려져 있다. 이들은 암모니아를 산화시켜 질소의 화학 형태를 바꾸는데 이는 해양생태계 먹이사슬의 기초를 형성하는 플랑크톤 성장의 중요한 역할을 한다.
연구팀은 예상보다 깊은 수심까지 해양온난화가 영향을 미치고 있다고 지적했다. 웨이 친 일리노이대 미생물학 교수는 "과거에는 심해가 바닷물 표층의 온난화에 비해 비교적 안전하다고 생각했지만, 이제는 1000m 이하 심해에서도 온난화 영향이 나타나고 있다"고 말했다.
연구팀은 이 미생물을 다양한 수온과 철분 농도 조건에 노출시키는 실험을 진행했다. 철은 이 미생물의 생존과 대사 활동에 필수요소다. 그 결과, 이 미생물은 철이 부족한 환경에서 수온이 상승할 경우 철 요구량을 줄이고 철 사용 효율을 높이는 방식으로 기온변화에 적응했다. 기온 상승과 영양 제한이라는 두 가지 스트레스 요인에 대응할 수 있는 대사조절 능력을 갖고 있다는 것이다.
또 이 실험 결과를 글로벌 해양 생지화학 모델과 결합해 분석한 바에 따르면 온난화가 진행되더라도 이 미생물 군집이 질소 순환과 해양 생산성 유지에 중요한 역할을 계속하거나 오히려 강화할 가능성이 있다고 연구팀은 설명했다.
다만 연구팀은 실제 해양 환경에서 이러한 현상이 나타나는지 추가 검증이 필요하다고 밝혔다. 이를 위해 연구팀은 올여름 연구선 '시쿨리악(Sikuliaq)'호를 이용해 시애틀에서 알래스카만을 거쳐 아열대 해역까지 현장조사를 진행할 예정이다. 이 조사에 20명의 연구자가 추가로 참여해 해양에 서식하는 고세균 군집을 분석하고 수온 변화와 금속 영양소 조건이 미생물 활동에 어떤 영향을 미치는지 확인할 계획이다.
이번 연구결과는 미국국립과학원회보(PNAS)에 게재됐다.
Copyright © NEWSTREE All rights reserved.
- 빈곤·교육 격차가 클수록 환경파괴 심해진다
- 현대차, 中업체와 손잡고 인니 EV배터리 재활용 순환체계 확보
- "배터리를 물에 담궈요?"…액침냉각 기술에 '주목'
- 해외직구 '유모차·세발자전거' 조심...유해물질 100배 초과
- IEA·美 사상 최대 '비축유 방출'에도...국제유가 5% '들썩'
- 캐나다 제설된 눈더미 '골머리'...소금과 유독물질 '하천 유입'
- [집중점검②] 중국산이 잠식한 태양광…국산품 되살리려면?
- [인터배터리 2026] 불황 겪은 배터리업계...'미래'보다 '상용화' 초점
- 기후변화에 전쟁까지 '겹악재'...이란 '물부족' 사태 더 심해져
- 국민연금 기후 주주관여 '반토막'…대상 기업 29개에서 13개로